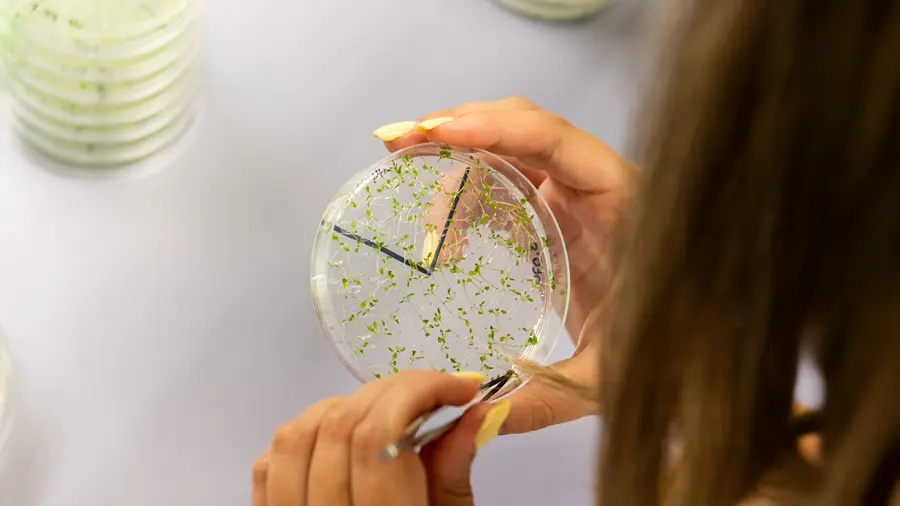
Imagen representativa de Institutos y centros de investigación por áreas de trabajo

Estructuras de investigación
Estructuras de investigación
La UPV cuenta con una amplia red de estructuras de investigación que impulsan la innovación y el conocimiento científico. Explora nuestros departamentos, institutos, centros y unidades especializadas.

Departamentos universitarios
Los departamentos universitarios son las unidades básicas de docencia e investigación de la Universidad. Agrupan áreas de conocimiento afines y desarrollan tanto la actividad docente como la investigadora.

Institutos universitarios de investigación
Los institutos universitarios de investigación son centros de gran relevancia e intensa actividad dedicados a la investigación científica, técnica y artística. Su creación es aprobada por la Generalitat Valenciana, de acuerdo con lo establecido en la LOU.
En cuanto a su naturaleza, pueden ser propios de la universidad -integrados por personal de la UPV y con dependencia exclusiva de ella- o mixtos, es decir, creados en colaboración con otros organismos públicos o privados mediante un convenio.

Estructuras propias de investigación
Bajo el nombre de estructuras propias de investigación, se integran los centros que se dedican a la investigación, desarrollo e innovación y tratan de dar respuesta a la demanda de productos tecnológicos y artísticos tanto de la Universidad como del entorno social. En cuanto a su naturaleza pueden ser centros de investigación propios, centros de investigación mixtos y concertados, y centros de investigación interuniversitarios.

Unidades de investigación conjunta (UIC)
Las Unidades de Investigación Conjunta (UIC) son alianzas temporales entre Estructuras de Investigación de la Universitat Politècnica de València y de otras entidades en un determinado ámbito científico-tecnológico o socioeconómico, que se establecen con el objeto de incrementar capacidad de I+D+i y compartir recursos. Pueden recibir también la denominación de unidad 'mixta' o 'asociada'.
Institutos y centros de investigación por áreas de trabajo
Explora nuestras estructuras de investigación organizadas por áreas temáticas: Agroalimentación, Biotecnología, Ciencias Sociales, Energía, Ingeniería Civil, Materiales, Medio Ambiente, Salud, TIC, Transporte y más.

Estructuras de apoyo a la investigación
La UPV cuenta con diversas estructuras que proporcionan soporte y recursos para la actividad investigadora, facilitando el desarrollo de proyectos de I+D+i y la colaboración con otras instituciones.







